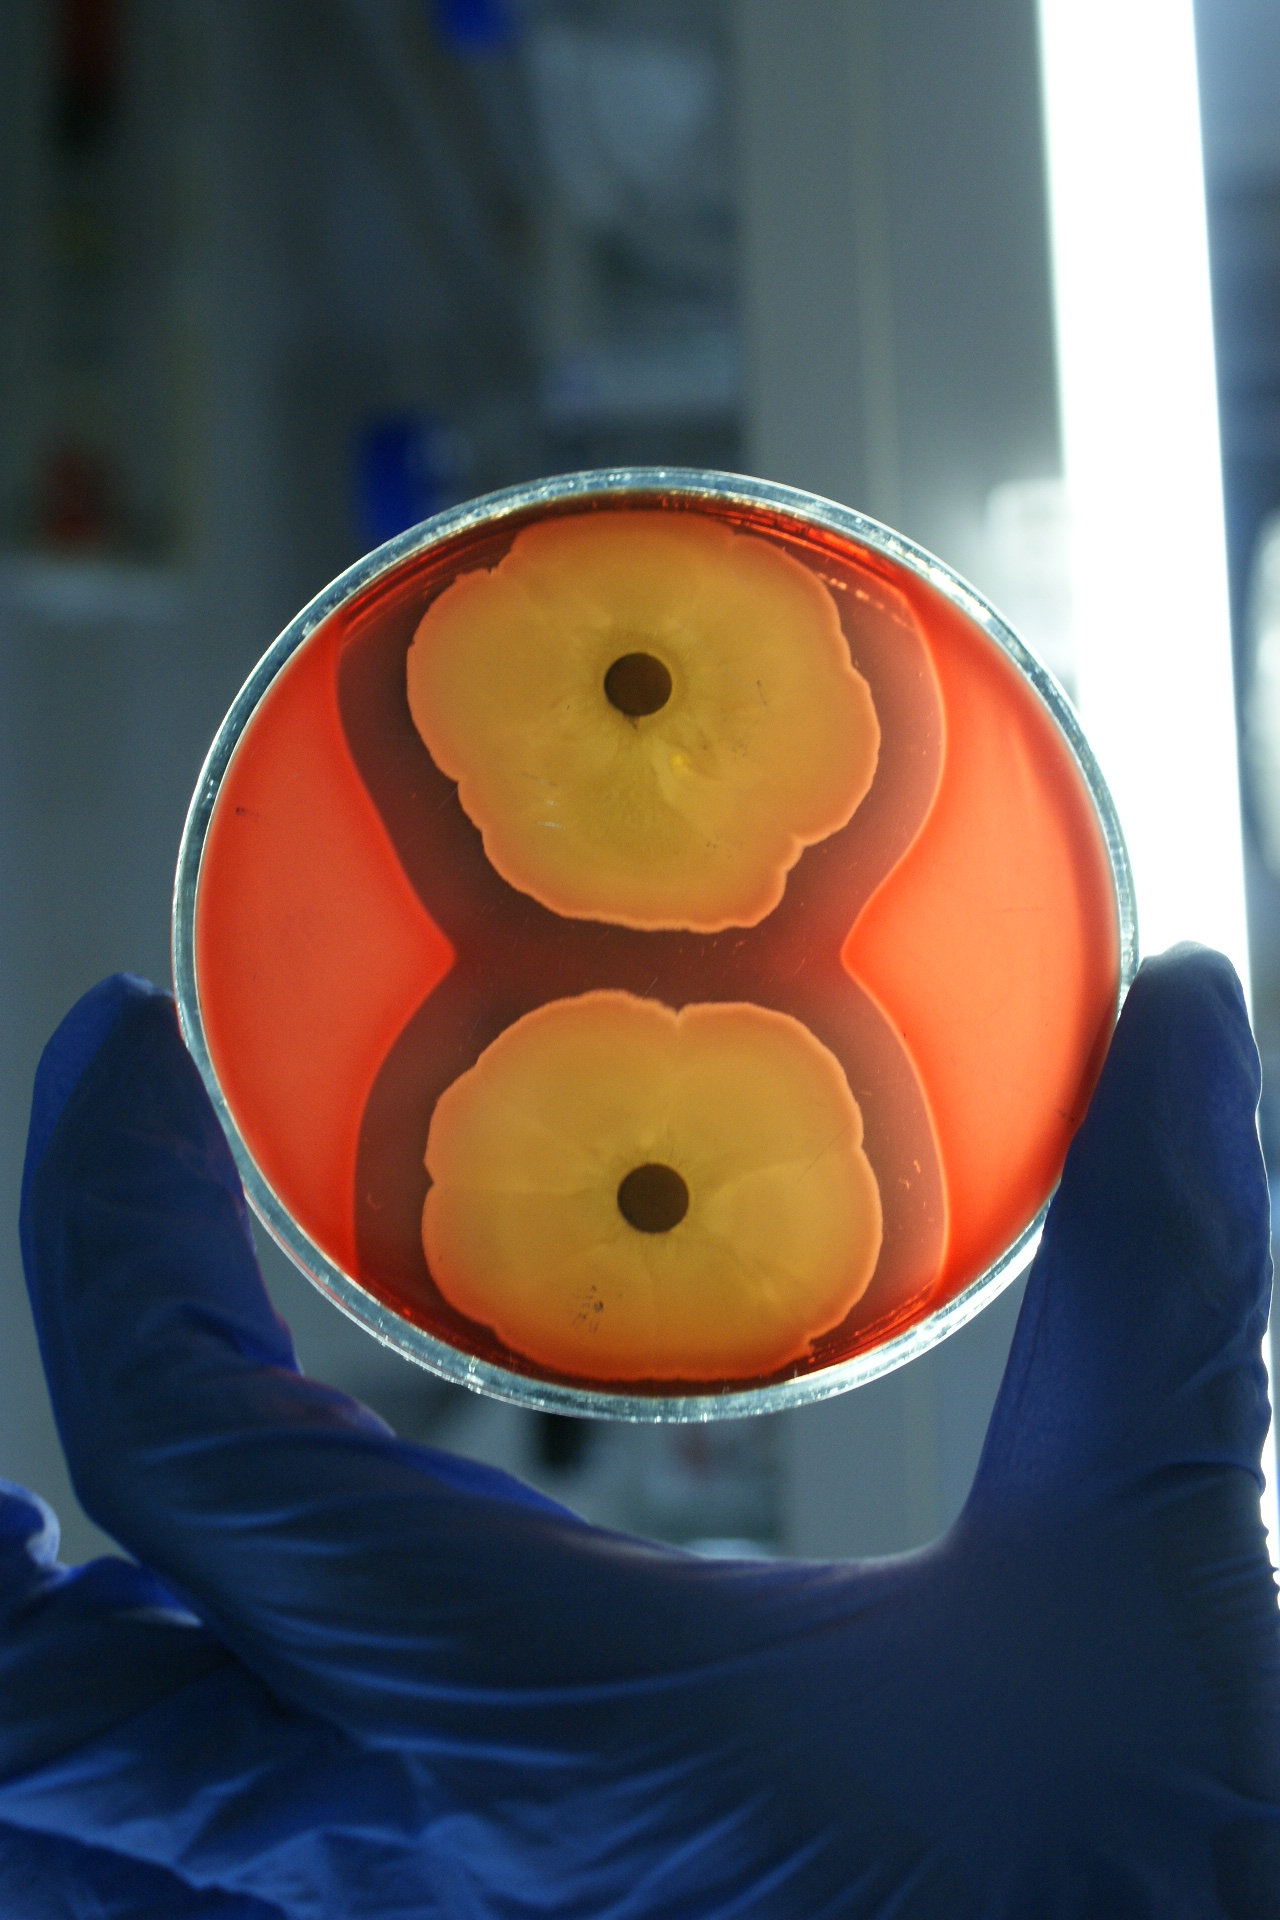
bioszczepionka

Biologia
Posiew szczepów na podłoże z agarem krwistym. Obserwowane tam strefy przejaśniania, powstałe w wyniku lizy erytrocytów, świadczą o potencjalnej zdolności wyselekcjonowanych szczepów do produkcji biologicznych związków powierzchniowo-czynnych.

Magdalena Pacwa-Płociniczak wraz z promotorką rozprawy doktorskiej prof. dr hab. Zofią Piotrowską-Seget w laboratorium

W dwóch probówkach widoczne są wytworzone emulsje oraz w trzeciej – brak takiej emulsji (czyli widoczne dwie warstwy: wodna ze szczepem i organiczna z węglowodorem)
Na Wydziale Biologii i Ochrony Środowiska UŚ prowadzone są badania nad zdolnościami bakterii do rozkładu toksycznych substancji organicznych.
- Szczegóły
- Autor: redpw
- Odsłon: 80
Na Wydziale Biologii i Ochrony Środowiska UŚ prowadzone są badania nad zdolnościami bakterii do rozkładu toksycznych substancji organicznych.
Najlepsze fotografie naukowe zaprezentowano w trakcie V Biennale Fotograficznego Unwiersytetu Śląskiego.
- Szczegóły
- Autor: Radek_A
- Odsłon: 89
Najlepsze fotografie naukowe zaprezentowano w trakcie V Biennale Fotograficznego Unwiersytetu Śląskiego.



Zintegrowany system wspomagający zarządzanie i ochronę zbiornika zaporowego (ZiZOZap) to nowatorski projekt uruchomiony w 2010 roku. Jego celem jest rozwiązanie problemów ekologicznych i funkcjonalnych zbiorników retencyjnych, w tym Goczałkowickiego Zbiornika Zaporowego
- Szczegóły
- Autor: drupalmig
- Odsłon: 70
Zintegrowany system wspomagający zarządzanie i ochronę zbiornika zaporowego (ZiZOZap) to nowatorski projekt uruchomiony w 2010 roku. Jego celem jest rozwiązanie problemów ekologicznych i funkcjonalnych zbiorników retencyjnych, w tym Goczałkowickiego Zbiornika Zaporowego
Ekologia jako podstawa systemu filozoficznego i etycznego. Wykład 1
- Szczegóły
- Autor: pawel.pawelczyk
- Odsłon: 78
Ekologia jako podstawa systemu filozoficznego i etycznego. Wykład 1
